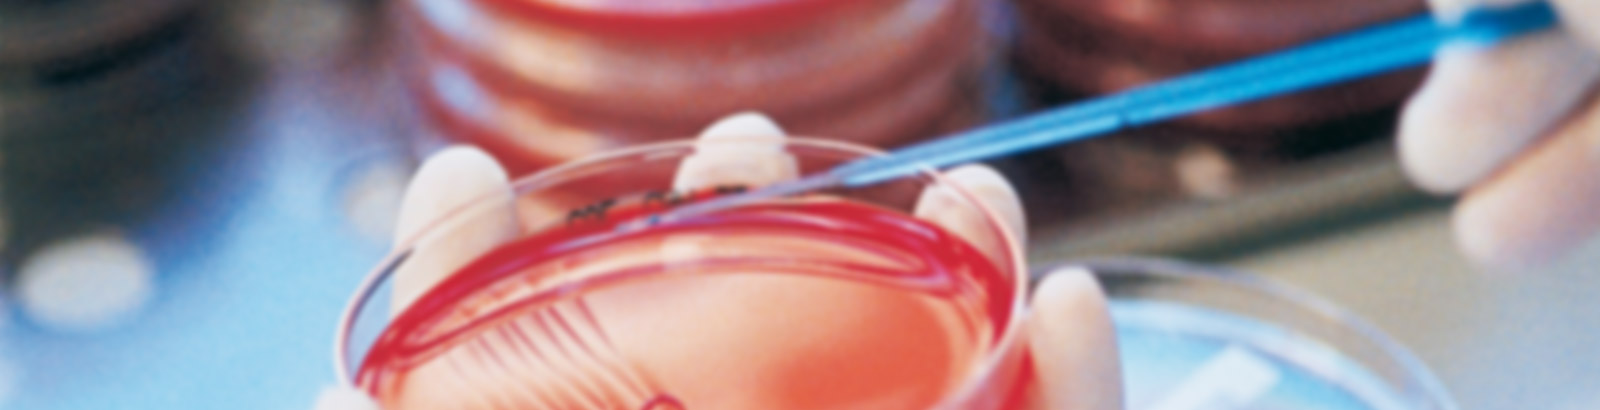
Labor Dr. Eberhard & Partner Dortmund, www.labmed.de

Bernice Eddy ( - ) est une virologue et épidémiologiste américaine. Elle et Sarah Elizabeth Stewart sont connues pour leurs découvertes liées aux polyomavirus, en particulier le polyomavirus SV40,.
Vie personnelle et éducation
Enfance et formation
Bernice Eddy nait en 1903 dans une famille de médecins à Glen Dale, en Virginie-Occidentale. Ses parents, Nathan E. Bernice Eddy et Clara C. née Griffith sont originaires d'Auburn, en Virginie-Occidentale. Elle est l'aînée de leurs quatre enfants. Bernice Eddy et sa mère déménagent à Marietta, Ohio, quelques années après la mort de son père. Bernice Eddy est diplômée du Marietta College en 1924. puis poursuit ses études à l'université de Cincinnati, où elle obtient une maîtrise en 1925 et un doctorat en bactériologie en 1927.
Biographie familiale
Bernice Eddy épouse Jerald G. Wooley en 1938, à l'âge de 35 ans, et le couple travaille au NIH en tant que bactériologistes. Ils ont deux filles, Bernice et Sarah. Jerald Guy Wooley meurt à l'âge de 64 ans, laissant Bernice Eddy alors âgée de 52 ans élever seule leurs deux filles, avec l'aide de sa propre mère.
Carrière au National Institutes of Health (NIH)
En 1930, Bernice Eddy rejoint le Service de santé publique des États-Unis (USPHS). En 1935, elle est mutée au National Institutes of Health (NIH) à Bethesda, Maryland, où elle rejoint la Division des contrôles biologiques, le département des NIH chargé de vérifier la qualité des vaccins distribués par le gouvernement fédéral des États-Unis. Elle est notamment chargée de tester différents vaccins contre la polio provenant de 5 sociétés différentes.
Test du vaccin contre la grippe
Pendant la Seconde Guerre mondiale, Bernice Eddy est chargée de vérifier la qualité des vaccins antigrippaux utilisés par l'armée américaine. Au sein de la Division des contrôles biologiques, elle et son équipe créent le premier test d'activité fiable pour les vaccins contre la grippe, afin que la qualité et l'efficacité soient constantes tout au long de la fabrication. Elle teste les vaccins contre la grippe de l'armée pendant 16 ans, jusqu'à ce qu'elle soit promue chef des tests des vaccins contre la grippe en 1944.
Recherche d'un vaccin contre la polio
Parallèlement à son travail de chef des essais sur les vaccins contre la grippe, Bernice Eddy entame des recherches sur les vaccins contre la polio au NIH en 1952. L'année 1952 est celle où le virus de la polio atteint son apogée aux États-Unis avec plus de 59 000 cas confirmés. En 1953, elle reçoit le NIH Superior Accomplishment Award pour ses recherches sur les vaccins contre la polio.
« Incident » de Cutter
En 1954, le NIH charge Eddy d'effectuer des tests de sécurité sur un lot de vaccins antipoliomyélitiques inactivés mis au point par Jonas Salk pour les laboratoires Cutter. Le vaccin antipoliomyélitique inactivé de Salk est un vaccin à virus inactivé devant être utilisé dans le cadre d'un programme national massif de vaccination. Le travail de Bernice Eddy consiste à tester les vaccins inactivés de cinq sociétés différentes. Après avoir testé les vaccins sur 18 singes, elle et son équipe découvrent que trois des six lots du vaccin des laboratoires Cutter contient des résidus de poliovirus vivant, de sorte que la moitié des singes présentent des symptômes semblables à ceux de la polio et sont paralysés. Ces résultats mettent en évidence un processus défectueux de fabrication de vaccins au sein des laboratoires Cutter. Eddy fait part de ses conclusions concernant les vaccins défectueux au chef du Laboratoire de contrôle biologique, William Workman. Cependant, Workman ne tient pas compte de cette alerte ; les problèmes identifiés avec le vaccin n'ont pas été transmis au comité consultatif d'homologation. Workman invalide les conclusions d'Eddy et l'écarte de la recherche sur la polio. Le vaccin défectueux est autorisé à être utilisé par le public. 120 000 doses de vaccin contre la polio contenant des souches du virus vivant de la polio ont été fabriquées et produites. Parmi les enfants qui ont reçu le vaccin, 40 000 ont développé une poliomyélite abortive (une forme moins agressive de la maladie qui ne touche pas le système nerveux central), 51 ont développé une poliomyélite paralytique — dont cinq enfants qui en meurent — et 113 autres sont paralysés par la forme la plus grave. Le 29 avril 1955, William Sebrell, directeur du NIH, préside une réunion pour examiner les protocoles de fabrication de Cutter. Eddy assiste également à cette réunion, qui n'aboutit à aucune conclusion sur ce que Cutter devrait faire différemment dans son processus de fabrication.
Le , le directeur associé du NIH, Leonard A. Scheele, annonce à la presse que le programme national de vaccination contre la polio est suspendu jusqu'à nouvel ordre. En conséquence, les fabricants de vaccins retiennent 3,9 millions de doses, et la suspension du programme de vaccination aux États-Unis est suivie par des suspensions analogues en Grande-Bretagne, en Suède, en Allemagne de l'Ouest et en Afrique du Sud. L'« incident Cutter » est l'un des pires désastres pharmaceutiques de l'histoire des États-Unis : il a exposé plusieurs milliers d'enfants au virus vivant de la polio lors de la vaccination. La Secrétaire à la santé, à l'éducation et au bien-être, Oveta Culp Hobby, ainsi que Sebrell, le directeur du NIH, démissionnent,.
Recherche sur les polyomavirus
Après l'incident Cutter en 1954, Bernice Eddy est mise sur la touche pour avoir dénoncé la présence de virus vivants dans le vaccin inactivé contre la polio de Jonas Salk. En 1956, alors qu'elles travaillent toutes deux à l'essai de vaccins contre le rhume, Sarah Elizabeth Stewart, sa collègue du NIH, lui demande de l'aider à cultiver l'agent responsable des tumeurs de la parotide chez la souris. Bernice Eddy accepte sans hésiter et les deux femmes définissent rapidement les caractéristiques de l'agent, qui n'est qualifié de virus dans leurs publications qu'en 1959. S'appuyant sur les travaux antérieurs de Ludwig Gross, Sarah Stewart et Bernice Eddy sont les premières à décrire un polyomavirus. Elles le font en injectant à des souris des organes broyés d'autres souris connues pour être leucémiques et en observant la croissance d'une tumeur cancéreuse non liée à la leucémie. Elles satisfont aux postulats de Koch pour démontrer que le polyomavirus peut causer le cancer en se transmettant d'un animal à l'autre. Stewart et Eddy continuent à tester la théorie selon laquelle les composants viraux sont capables d'induire des tumeurs. Elles testent des extraits de tumeurs provenant d'embryons de singe et de souris, et constatent que les embryons de souris contiennent une plus grande quantité d'agents viraux cancérigènes, ce qui les amènent à penser que les virus peuvent être des agents cancérigènes. Le virus peut être absorbé par des érythrocytess de cobaye, de hamster ou d'humain lors d'une hémagglutination provoquée par le froid. Elles concluent également que le polyomavirus est capable de provoquer 20 types différents de tumeurs chez la souris. Eddy et Stewart démontrent que le virus provoque la nécrose et la prolifération des cellules en culture cellulaire, qu'il est hautement antigénique et qu'il entraîne la formation d'anticorps spécifiques chez les animaux infectés, que des tumeurs se développent ou non. Sur la suggestion d'Eddy, le virus est qualifié de polyome, ce qui signifie beaucoup de tumeurs, puis il est baptisé Stewart-Eddy ou SE polyoma virus, d'après leurs noms de famille respectifs. Les résultats de leur collaboration leur valent d'être reconnues par le magazine Time en 1959, avec un article de couverture sur les agents viraux nouvellement découverts qui causent le cancer.
Rivalité avec Ludwik Gross
Ludwik Gross et Sarah Stewart ont mené des recherches sur les virus cancérigènes simultanément et séparément, et étaient au courant de leurs travaux respectifs depuis au moins décembre 1952. Tous deux avaient découvert indépendamment des tumeurs de la parotide à peu près en même temps, et chacun a reproché à l'autre de ne pas avoir cité ses travaux. Lorsque Stewart et Bernice Eddy, ainsi que Borgese, publient en 1958 leur article sur un virus induisant une tumeur de la parotide (appelé plus tard SE polyomavirus), les travaux antérieurs de Gross sur le virus de la parotide ne sont pas cités. La rivalité atteint son paroxysme en 1958, lorsque Jacob Furth attribue la découverte du virus de la tumeur parotidienne à la fois à Stewart et à Gross. Alors que Gross affirme être le premier découvreur du virus, Stewart maintient qu'elle et Bernice Eddy l'ont découvert indépendamment. Lorsque le virus est rebaptisé "SE polyomavirus" pour Stewart et Bernice Eddy, Gross estime que cela diminue son rôle dans la découverte, et il écrit plusieurs lettres à ses pairs pour défendre son point de vue. Plus tard, Bernice Eddy sera d'accord et déclarera que "Sarah était très agressive. Nous lui avons donné un nom. Nous n'aurions probablement pas dû" et "Il (Gross) avait ce virus avant nous. Il n'y avait aucun doute".
Recherche sur le virus SV40
En 1959, Bernice Eddy commence à mener des études de sécurité sur les vaccins contre la polio, qui utilisent des virus cultivés dans des cellules rénales de singe. En 1961, elle montre qu'un extrait de cellules rénales de singe rhésus (RMKC) utilisé dans la création du vaccin contre la polio provoque des tumeurs chez les hamsters nouveau-nés. Plus précisément, 109 des 154 souris auxquelles on a injecté des extraits de RMKC ont montré des signes de croissance tumorale Les extraits de ces néoplasmes sont transplantés dans un nouveau groupe de souris où une croissance tumorale similaire est observée. Les transplantations d'extraits de tumeurs sont effectuées sur cinq générations de souris, et tous les membres de la dernière génération présentent une croissance tumorale. En 1962, Eddy présente des preuves que l'agent oncologique présent dans le sérum RMKC est capable d'induire des tumeurs histologiquement similaires dans les mêmes conditions que le SV40, et que ces tumeurs présentent des propriétés différentes de celles du virus polyoma SE, qui est alors le seul autre matériel biologique connu pour être capable d'induire des tumeurs chez presque tous les hamsters injectés en tant que nouveau-nés. Comme pour le SV40, les extraits de RMKC restent infectieux après passage à travers des filtres et après des niveaux similaires d'exposition à l'éther diéthylique, à la chaleur et au stockage à −70 °C. Eddy apporte également la preuve que les extraits de RMKC sont inhibés (les tumeurs ne se développent pas) dans des conditions qui inhibent également le développement des tumeurs du SV40. Cela inclut l'inhibition chez les animaux qui ont reçu des extraits de RMKC combinés à du sérum de lapin anti-SV40. Compte tenu de la prépondérance des preuves, son article conclut que l'agent oncologique contenu dans les extraits de RMKC est identique au virus SV40.
Cette découverte revêt une importance à la fois pratique et théorique. D'un point de vue pratique, la découverte explique les origines de la contamination généralisée de divers stocks de virus de semence et de vaccins vivants contre la polio par le SV40, dont il avait été question dans un article de 1960 rédigé par Ben Sweet et Maurice Hilleman,. Bernice Eddy a suggéré que cette contamination pourrait être évitée à l'avenir en criblant les cultures de cellules rénales de C. aethiops pour détecter les changements cytopathiques (cellulaires) caractéristiques que le SV40 provoque. Cette découverte a conduit Merck à retirer volontairement son vaccin antipoliomyélitique à virus inactivé. Sur le plan théorique, elle s'ajoute à un ensemble croissant de preuves que le singe, comme la souris, peut héberger des virus oncogènes susceptibles d'affecter d'autres espèces animales.
La question de savoir si le SV40 provoque le cancer chez l'homme reste cependant controversée. En 1998, l'Institut national du cancer a entrepris une vaste étude, en utilisant les informations sur les cas de cancer de la base de données SEER de l'institut. Les résultats publiés de l'étude ont été jugés de peu de valeur dans une revue de 2002 qui a demandé des investigations supplémentaires. Une autre étude de grande envergure menée en Suède a examiné les taux de cancer de 700 000 personnes qui avaient reçu un vaccin antipoliomyélitique potentiellement contaminé jusqu'en 1957 ; l'étude n'a révélé aucune augmentation de l'incidence du cancer entre les personnes ayant reçu des vaccins antipoliomyélitiques contenant du SV40 et celles qui n'en ont pas reçu. Le développement de tests améliorés pour la détection du SV40 dans les tissus humains sera nécessaire pour résoudre la controverse.
Autres recherches notables
Recherche sur la lèpre
En 1937, Bernice Eddy et ses collègues étudient de multiples aspects de Mycobacterium leprae, la bactérie responsable de la lèpre, afin d'obtenir des informations précieuses pour de futurs diagnostics. L'une des études menées par Bernice Eddy consiste à trouver de nouveaux milieux sur lesquels cultiver Mycobacterium leprae en laboratoire. Une autre étude notable réalisée par Bernice Eddy comprend la recherche sur certains comportements de la bactérie de la lèpre en présence de leucocytes.
Retraite et décès
Bernice Eddy prend sa retraite du NIH en 1973, à l'âge de 70 ans. Lors de sa retraite, elle reçoit plusieurs récompenses, dont une citation spéciale du secrétaire du département de la santé, de l'éducation et du bien-être (HEW). Bernice Eddy meurt le des suites d'un arrêt cardiopulmonaire.
Prix et distinctions
Bernice Eddy reçoit un doctorat honorifique en sciences du Marietta College en 1955, et le ministère américain de la Santé, de l'Éducation et de la Protection sociale lui décerne une médaille pour services supérieurs en 1967. Elle est ensuite honorée par le NIH Director's Award en 1977. Il s'agit de la cérémonie de remise de prix la plus prestigieuse, qui récompense les grandes réalisations de l'ensemble des NIH. Bernice Eddy et sa partenaire de recherche Sarah E. Stewart ont été nommées deux fois pour le prix Nobel.
Études publiées
- Bernice E. Bernice Eddy, « A Simplified Procedure for Detecting Cross Reactions in Diagnostic Antipneumococcic Serum », Public Health Reports, vol. 59, no 32, , p. 1041–1045 (ISSN 0094-6214, DOI 10.2307/4584990, JSTOR 4584990, lire en ligne)
- Bernice E. Bernice Eddy, « Cross Reactions between the Several Pneumococcic Types and Their Significance in the Preparation of Polyvalent Antiserum », Public Health Reports, vol. 59, no 15, , p. 485–499 (ISSN 0094-6214, DOI 10.2307/4584847, JSTOR 4584847, lire en ligne)
- Bernice E. Bernice Eddy, « A Study of Pneumococcus Typing Serums for the Purpose of Standardizing a Test for Potency », Public Health Reports, vol. 55, no 9, , p. 347–361 (ISSN 0094-6214, DOI 10.2307/4583194, JSTOR 4583194, lire en ligne)
- B. E. Bernice Eddy, « Hemoglobinophilic Bacilli from Infantile Meningitis », Journal of Infectious Diseases, vol. 52, no 2, , p. 242–245 (ISSN 0022-1899, DOI 10.1093/infdis/52.2.242, lire en ligne)
- B. E. Bernice Eddy, « Search for Protective, Bacteriophagic and Enzymatic Agents in Pneumonic Sputums », Journal of Infectious Diseases, vol. 42, no 5, , p. 449–460 (ISSN 0022-1899, DOI 10.1093/infdis/42.5.449, lire en ligne)
- Bernice E. Bernice Eddy, « A Study of Cross Reactions among the Pneumococcic Types and Their Application to the Identification of Types », Public Health Reports, vol. 59, no 14, , p. 451–468 (ISSN 0094-6214, DOI 10.2307/4584838, JSTOR 4584838, lire en ligne)
- Alice L. Chinn et Bernice E. Bernice Eddy, « Report of a New Type of Pneumococcus Which Crosses with Types X, XI, XX, XXIX, and XXXI Antipneumococcic Serums », Public Health Reports, vol. 56, no 2, , p. 62 (ISSN 0094-6214, DOI 10.2307/4583579, JSTOR 4583579, lire en ligne)
- Bernice Bernice Eddy, « Neoplasms in Guinea Pigs Infected with Se Polyoma Virus », The Journal of Infectious Diseases, vol. 107, no 3, , p. 361–368 (PMID 13725645, DOI 10.1093/infdis/107.3.361, JSTOR 30101899, lire en ligne)
- T. G. Ward et B. E. Bernice Eddy, « An Antigenically Distinct Subtype of Influenza Virus A Which is Virulent for Mice in Primary Passage of Allantoic Fluid », Science, vol. 112, no 2913, , p. 501–503 (ISSN 0036-8075, PMID 14787447, DOI 10.1126/science.112.2913.501, Bibcode 1950Sci...112..501W, lire en ligne)
- Bernice Bernice Eddy, « Virus and Rickettsial Diseases », American Journal of Public Health and the Nation's Health, vol. 41, no 9, , p. 1133–1134 (ISSN 0002-9572, PMCID 1525832, DOI 10.2105/AJPH.41.9.1133-b)
Notes et références
Voir aussi
Liens externes
- Portail des États-Unis
- Portail de la médecine
- Portail de la virologie
- Portail de Cincinnati
- Portail de la Virginie-Occidentale